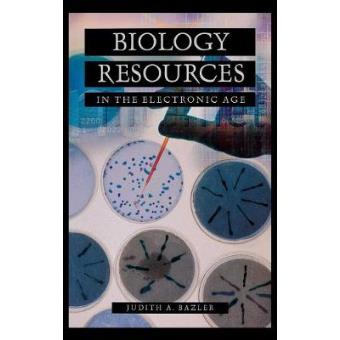
Biology Resources in the Electronic Age - Hardback - 2003 - 1

Biology Resources in the Electronic Age - Hardback - 2003
Judith Bazler
Resumo
Lists and reviews the most useful Web sites that provide information on key topics in biology.
Year of publication: 2003
Pagination: 304 pages
Format: Hardback
Serie: Science Resources in the Electronic Age
Year of publication: 2003
Pagination: 304 pages
Format: Hardback
Serie: Science Resources in the Electronic Age

Biology Resources in the Electronic Age - Hardback - 2003
Resumo
Lists and reviews the most useful Web sites that provide information on key topics in biology.
Year of publication: 2003
Pagination: 304 pages
Format: Hardback
Serie: Science Resources in the Electronic Age
Year of publication: 2003
Pagination: 304 pages
Format: Hardback
Serie: Science Resources in the Electronic Age
Publicidade
Avaliações dos nossos clientes
Biology Resources in the Electronic Age - Hardback - 2003
Sê o primeiro a dar
a tua opinião sobre este produto
Características
- Editora
-
ABC-CLIO
- Dimensão
-
246 x 158 x 27
- Peso
-
600
- Tema
-
Biology, life sciences
- Origem
-
United States
- EAN
-
9781573563802
Publicidade
Publicidade